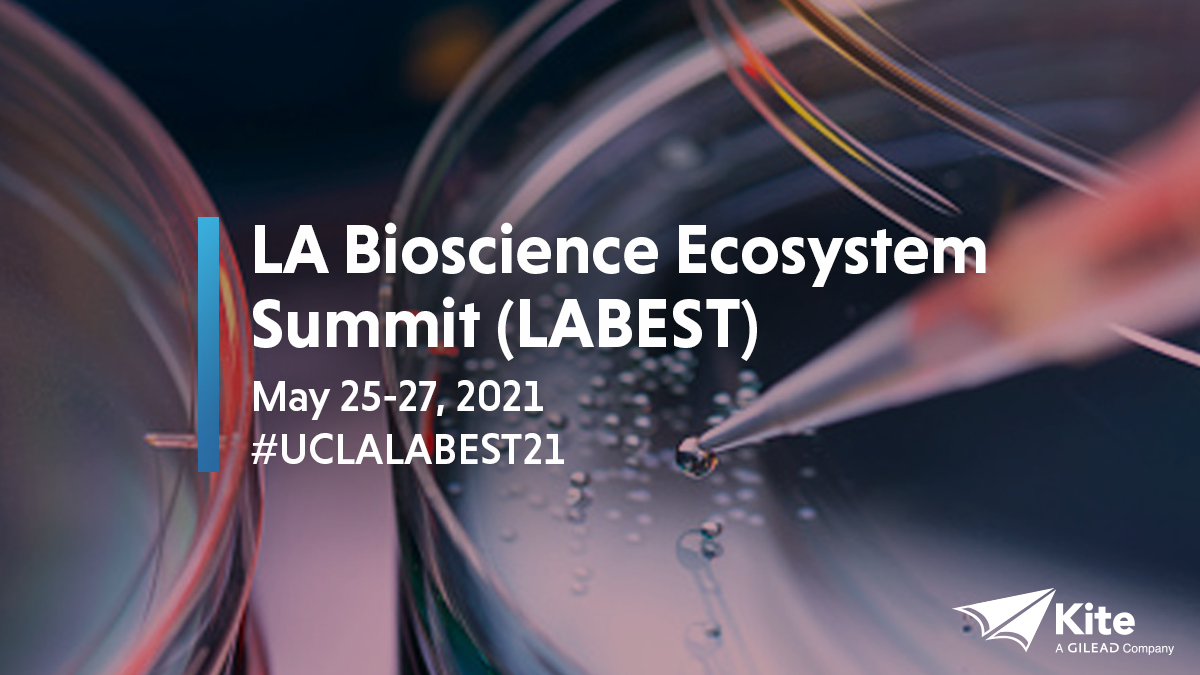

Kite Pharma is an American biotechnology company that develops cancer immunotherapy products, with a primary focus on genetically engineered autologous CAR T cell therapy, a cell-based therapy which relies on chimeric antigen receptors and T cells. As Senior Art Director with Real Chemistry, I collaborated with my team on a set of social style guidelines and created a variety of animated and static social media content.
One of my favorite pieces is this animated history of CAR T-cell Therapy:
Social Guidelines:








Static Social Content:

Animated Social Content:
